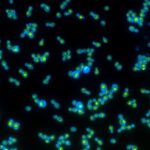
Nouvelles perspectives sur l’évolution, les biocarburants et le vieillissement cellulaire – Des biologistes ont développé une levure alimentée par la lumière SciTechDaily

Dire Donald Trump est un misogyne n’est pas tout à fait exact. Il aime les femmes, mais seulement un type de femme très spécifique. Il aime le genre de femme malléable, docile. Il est absolument allergique aux femmes qui parlent franchement. C’est pourquoi les femmes aiment E.Jean Carroll (et Nikki Haley) se sont vraiment mis sous sa peau en lui tenant tête.
Lorsque Carroll a rendu public pour la première fois ses allégations d’agression sexuelle contre Trump en 2019 – pour lesquelles nous avons été reconnus responsables l’année dernière – l’ancien président l’a soumise à une campagne de diffamation, tout comme il l’a fait avec ses autres qui ont parlé de lui (comme Daniels orageux) et avec ses rivaux politiques (comme Hillary Clinton). Trump a accusé Carroll d’avoir tout inventé : il a affirmé qu’elle était un « travail farfelu » orchestrant un « travail d’escroquerie » – et a même insisté, comme quasi-défense, sur le fait qu’elle n’était « pas mon type ». Carroll a ensuite déposé une plainte en diffamation, alléguant que Trump avait déchiré sa réputation « en lambeaux ». En fin de compte, un jury a accepté : la semaine dernière, dans un incroyable point culminant d’une épreuve de plusieurs années, Trump a été condamné à lui verser 83,3 millions de dollars de dommages et intérêts. Et pourtant, même une fois la poussière retombée, Trump a eu le culot – ou la folie – de cracher encore plus invectives contre Carroll, qualifiant son cas de « canular » et affirmant qu’il s’agissait d’une erreur judiciaire.
J’ai un lien avec cette affaire : je l’ai présentée à un avocat George Conway, qui l’a finalement aidée à trouver une représentation juridique.
Si le procès de Carroll a révélé quelque chose, c’est que les femmes – et particulièrement les femmes qui s’expriment ouvertement – déclenchent Trump. Depuis Megyn Kelly et Rosie O’Donnell à Kamala Harris et Alexandrie Ocasio-Cortez, les femmes de tous bords ont ressenti la colère du sexisme de l’ex-président. Comme Sophie Gilbert a écrit le mois dernier dans L’Atlantique, « La misogynie que Trump incarne et défend est moins une question de haine que d’application : soulignant son exigence que les femmes aient une certaine apparence et se comportent d’une certaine manière, que nous nous conformions à ses désirs et nous soumettions à notre fonction sociale requise. » En d’autres termes, vous pouvez être une femme dans le monde de Trump, mais seulement si vous êtes le genre de femme que Trump aime.
C’est pourquoi l’ancienne ambassadrice de l’ONU Nikki Haley, qui poursuit sa campagne présidentielle de longue haleine contre Trump, est en train de devenir rapidement sa nouvelle bête noire. Trump a ouvertement critiqué l’une de ses robes ; s’est moquée de son prénom, Nimrata, et a pris l’habitude de la traiter de « cervelle d’oiseau ». Trump attaque même Haley quand il ne le veut pas : la semaine dernière, lors d’un discours dans le New Hampshire, Trump l’a confondue avec Nancy Pelosi tout en répétant une théorie du complot sans fondement sur l’attentat du 6 janvier. « Nikki Haley… savez-vous qu’ils ont détruit toutes les informations, toutes les preuves, tout, tout supprimé et détruit ? » a-t-il déclaré, suggérant que les démocrates ont délibérément refusé la sécurité au Capitole. « Tout cela, à cause de beaucoup de choses, comme par exemple que Nikki Haley est en charge de la sécurité. Nous lui avons offert 10 000 personnes, des soldats, de la Garde nationale, tout ce qu’ils veulent. Ils l’ont refusé.
Malgré son insistance incessante à être mentalement plus vif que jamais, Trump a, en fait, confondu Pelosi et Haley sept – oui, Sept-fois. Et Haley, de son côté, a sauté sur l’occasion pour souligner ce point de confusion. « Hier soir, Trump était à un rassemblement et il n’arrêtait pas de me mentionner à plusieurs reprises pourquoi je n’avais pas pris la sécurité pendant les émeutes du Capitole », a-t-elle déclaré à une foule dans le New Hampshire au début du mois. «Pourquoi je n’ai pas mieux géré le 6 janvier. Je n’étais même pas à Washington le 6 janvier. Je n’étais pas en fonction à ce moment-là.
Bien qu’elles puissent être assises de différents côtés de l’allée, Pelosi et Haley ont un point commun : ce sont toutes deux des femmes qui ont réussi à se mettre dans la peau de Trump. Ils ont supporté le prix d’être les principaux antagonistes de Trump, et ils ne sont pas seuls. Procureur du comté de Fulton Fani Willis, qui intente une action RICO contre Trump pour tentative d’ingérence dans les élections géorgiennes de 2020, a fait l’objet de menaces de mort et d’insultes racistes de la part des partisans de Trump. La même chose peut être dite pour le procureur général de New York Létitia James, qui porte une énorme affaire de fraude civile contre Trump. (James, comme Carroll, a en fait amené Trump à comparaître devant le tribunal – ce qui peut montrer à quel point il apprécie son entreprise immobilière familiale, sans aucun doute la pierre angulaire de son mythe de milliardaire.)
Cependant, en ce qui concerne les hommes dans la vie de Trump, l’ancien président a largement réussi à les renverser avec peu ou pas de résistance. Cela n’est nulle part plus vrai qu’au Congrès, où les Républicains de la Chambre restent à son écoute et appellent à faire sauter toute législation que l’ex-président juge appropriée. Au lieu de cela, ce sont historiquement les femmes qui ont tenu tête à Trump. Par exemple, dimanche, interrogée sur le jugement Carroll, Haley a refusé de se prosterner devant Trump comme l’ont fait la plupart des primaires (dominées par les hommes) du Parti républicain. « Je fais absolument confiance au jury et je pense qu’ils ont pris leur décision sur la base des preuves », a déclaré le candidat à la présidentielle sur NBC. Rencontrer la presse. Le peuple américain, a-t-elle ajouté, « voit qu’il est complètement distrait, il voit qu’il se déchaîne sur le fait qu’il est une victime, et je pense que c’est exactement ce que nous n’avons pas besoin d’un leader fort ».
Bien sûr, personne ne s’attend à ce que Haley l’emporte sur Trump et décroche la nomination du GOP. Mais chaque fois qu’il insulte son intelligence, son héritage ou sa tenue vestimentaire, il montre au peuple américain qui il est vraiment – ce qui pourrait avoir de l’importance pour l’ensemble.
Tenir tête à Trump fait peur ; cela pourrait mettre en péril les moyens de subsistance personnels et professionnels de chacun, et c’est précisément la raison pour laquelle les républicains refusent de le faire. Dans le cas de Carroll, il est difficile d’imaginer qu’elle ait voulu passer la première année de ses 80 ans assise dans une salle d’audience, affrontant un tyran et pataugeant dans une mer de menaces de mort tout en étant transportée d’un endroit à l’autre par une sécurité privée. Mais elle l’a fait parce qu’elle sentait qu’elle devait le faire. Et si les gens au pouvoir avaient suivi son exemple en 2016 ou 2020, alors Trump aurait peut-être été renvoyé dans les caniveaux de la télé-réalité au lieu d’avoir une autre chance à la Maison Blanche.